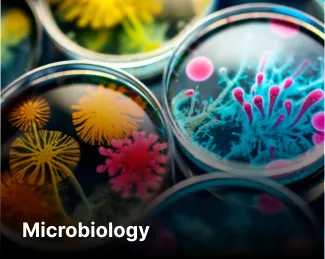
Microbiology

About This Course
The B.Sc. (Hons.) programs at Shobhit University are approved by UGC and crafted to offer students practical and holistic education in various scientific disciplines. Our program emphasizes hands-on learning, advanced research, and the application of concepts in real-world scenarios, enabling students to excel in diverse scientific professions.
Currently, we offer specializations, which include in-demand options like Agriculture, Nutrition & Dietetics, Microbiology, Biotechnology, Biomedical Science.
We take pride in our cutting-edge infrastructure, world-renowned faculty, and close industry collaborations that help students gain expertise in their respective fields. Our faculty comprises accomplished professionals who provide comprehensive academic support to students and assist them in achieving their academic and career aspirations.
If you aspire to excel in the fields of agriculture, IT, and applied sciences, our Bachelor of Science programs are an excellent starting point for your journey.
Why choose Shobhit University for your B.Sc. Honors
Legacy
-
37+ years of outstanding legacy
-
Alumni in more than 120 countries
Shobhit Edge
-
Technology equipped classrooms
-
ASPIRE - MSME Technology Business Incubator
-
Hi-Tech Wi-fi enabled campus
-
Start-up Funding Opportunities
-
NCC Battalion - 70 UP NCC BTN Meerut
-
Cutting edge academic programs in partnership with industry leaders
Admission Details
Eligibility
-
Candidates who have completed (10+2) / Intermediate / Higher Secondary from any approved board with PCM/PCB/Agriculture are eligible.
-
Candidates with valid CUET (UG) / SUNET scores can apply for admission